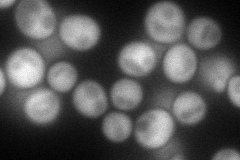
YPR041W
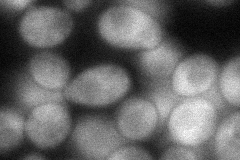
YPR041W
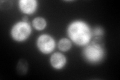
YPR041W
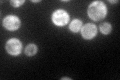
YPR041W

View description
Translation initiation factor eIF-5; N-terminal domain functions as a GTPase-activating protein to mediate hydrolysis of ribosome-bound GTP; C-terminal domain is the core of ribosomal preinitiation complex formation
Localization:
Intensity:
Fold change:
Significance:
-
C’ GFP library in SD

cytosol274.15 -
N' NOP1pr-GFP in SD
cytosol117.51 -
N' TEF2pr-mCherry in SD

cytosol141.097 -
N' NATIVEpr-GFP in SD

cytosol442.141 -
N' TEF2pr-VC and Cyto-VN in SD
cytosol55.936 -
C’ GFP library in SD+DTT
cytosol283.881.03No -
C’ GFP library in SD+H2O2

cytosol341.951.24No -
C’ GFP library in Starvation Media
cytosol127.360.46Yes -
C’ GFP library on the background of Pup2-DaMP

cytosol -
C’ GFP library on the background of CCT mutant

cytosol276.1011.00706No
